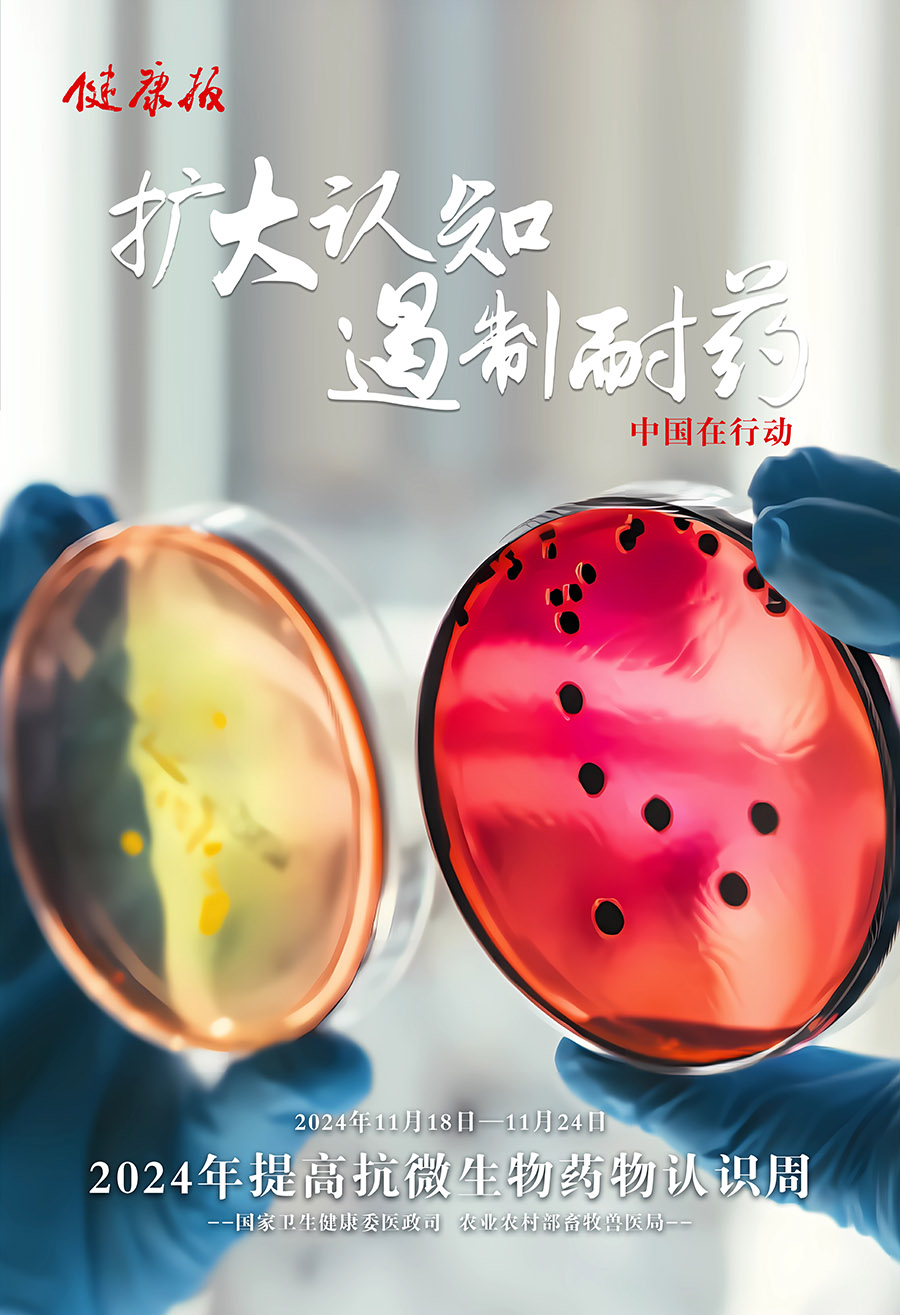
2.jpg

2024年提高抗微生物藥物認(rèn)識(shí)周
2024年11月18日-24日是2024年“世界提高抗微生物藥物認(rèn)識(shí)周”,今年的活動(dòng)主題是“教育 倡導(dǎo) 立即行動(dòng)”。微生物耐藥問題,已成為全球公共健康領(lǐng)域面臨的重大挑戰(zhàn),也是各國(guó)政府和社會(huì)廣泛關(guān)注的社會(huì)性問題。
本次活動(dòng)意在廣泛宣傳抗微生物藥物合理使用知識(shí)及如何正確使用抗病毒藥物、抗菌藥物等;提高社會(huì)公眾和醫(yī)務(wù)人員對(duì)耐藥危機(jī)的認(rèn)識(shí),減少不必要的藥物使用,積極遏制微生物耐藥發(fā)展與蔓延。

CopyRight 2004-2017 安陽市眼科醫(yī)院 All Rights Reserved!
地址:安陽市文明大道東段 郵箱:eye3679002@126.com 電話 0372-3395002
品牌支持:安陽藍(lán)海信息技術(shù)有限公司